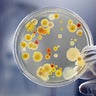
sworna kumari chithiraivelu, profile picture

sworna kumari chithiraivelu
No infographics yet
No likes yet
Personal Information
Organization / Workplace
TANUVASOccupation
Ph.D scholarIndustry
Agriculture / Forests / Fisheries
Website
swormagecollectionsAbout
Research student
Organization / Workplace
TANUVASOccupation
Ph.D scholarIndustry
Agriculture / Forests / Fisheries
Website
swormagecollectionsAbout
Research student